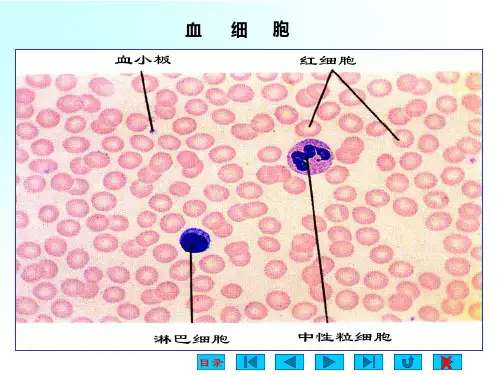

血浆胶体渗透压:维持和调节毛细血管内外水平衡, 保持正常的血浆容量具有重要作用。
第三节 血细胞
一、 红细胞
红细胞是血液中数量最多的一种血细胞
正常男性约 (4~5.5)×1012/L,平均 5.0×1012/L,
正常女性 约 (3.5~5)×1012/L ,平均 4.2×1012/L
正常红细胞双凹圆碟形,中间薄周围厚,直径 约7-8μm,容积约为90μm3
一、血液的组成 血液又叫全血
二、血液的理化性质
(一)颜色
血液的颜色,主要取决于红细胞中血红蛋白的颜色 。
(二)密度
血液的比重主要取决于红细胞的浓度,其次决定于 血浆蛋白的浓度。
(三)粘滞性
血液的粘滞性为水的4~5倍,血浆的粘滞性为水 的1.6~2.4倍。
(四)酸碱度
正常人血浆的pH值为7.35~7.45(平均为7.4), 变动范围极小,
三、血液的基本功能
(一)运输功能 (二)调节功能 (三)防御和保
护功能
第二节 血 浆
血浆是含有多种溶质的水溶液,属体液 的一部分。血浆和全血一样,从血管中 流出,如不加抗凝剂 就会自行凝固。
一、血浆的化学成分
血浆蛋白:包括白蛋白、球蛋白和纤维蛋白原
有机物
非蛋白有机物:包括尿素、尿酸、肌酐、肌酸和氨基酸等
在功能上T细胞主要与细 胞免疫有关,B细胞则主要 与体液免疫有关。
三、血小板
(一)血小板的数量
血小板是骨髓巨核细胞的细胞质脱落 形成的具有代谢力的细胞,呈梭形或椭圆 性.
正常值(100~300)×109/L.正常变动范 围不超过10%.血小板含量≤50× 109/L,称 为血小板减少,可产生出血倾向;血小板数 量超过1000 × 109/L,称为血小板过多,易 发生血栓.

![生理学3血液[可修改版ppt]](https://uimg.taocdn.com/bd8dacf1af45b307e97197b3.webp)




